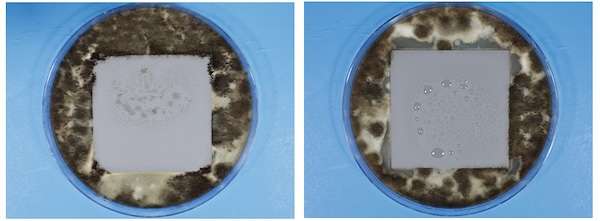

エービーシー商会(東京都千代田区)は、水性硬質ウレタン系塗り床材「タフクリートシリーズ」に、防カビ性能を付加した工法と、耐候性を向上する工法の2種類を追加した。
「タフクリートシリーズ」は、耐衝撃性、耐薬品性、抗菌性にすぐれたシームレスな塗り床材。HACCP International認証を取得(一部除く)しており、厨房や食品工場など、高度な衛生管理を求められる場所に幅広く採用されているという。
今回新たにラインアップした「LR防カビB工法」は、専用の防カビ添加剤を配合。
「JIS Z 2911 カビ抵抗性試験 プラスチック製品方法 B」という極めて厳しい評価基準に基づく試験を行ったところ、カビの繁殖抑制が確認されたとする。
左:タフクリートMH(MH工法)
右:タフクリートMH(MH-LR防カビB工法)
もう1つの「ネオクリートLR工法」は、優れた難黄変性と耐候性により変色が起こりにくいため、床が見えるオープンキッチン型店舗や商業施設などに適する。

■工法図
厚さ約6/9mm
①欠込目地(10×10mm) ②下塗 ③上塗+表面調整
■関連記事
コンクリート床に耐久性・ツヤを与える省施工な無機系トップコート
仕上げ厚0.5mm、テラゾー・天然石床の風合いを表現
住宅ビジネスに関する情報は「新建ハウジング」で。試読・購読の申し込みはこちら。




























